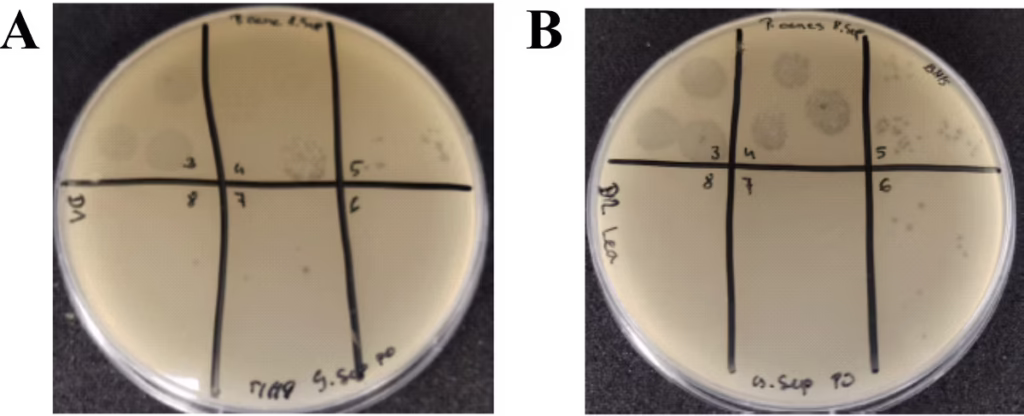

Paul Lawrence, Brianna Scacchi, Julie Fisher, and Joseph Ceccoli
ABSTRACT
Bacteriophages are a unique group of viruses that exclusively target specific bacteria species, represent the most abundant form of life on Earth, and are the active component in a bacterial countermeasure dating back to the early 20th century. Unlike antibiotics, bacteriophages are very species specific. The looming threat of antibiotic resistance demands new approaches to combating bacteria being researched. Moreover, the importance of the skin microbiome to maintaining healthy skin has come to the forefront, warranting new technologies be investigated to modulate it for beneficial effect. One such condition is skin blemishes, which develop upon discordant P. acnes growth. Here, we propose the development of topical formulations infused with bacteriophage specific to P. acnes so as to decrease the levels of P. acnes present on the skin and by extension, mitigate its negative impact with reduced skin blemishes. P. acnes were cultivated under anaerobic conditions and evaluated for biofilm formation. Small fully turbid cultures of P. acnes were inoculated with a single P. acnes bacteriophage species. Post-incubation for >24 hours, the cultures became fully translucent, demonstrating their capacity to eliminate planktonic P. acnes. This was repeated to increase the bacteriophage stock, and upon full lysis, the culture was 0.2 µm filtered and evaluated for endotoxin and cytotoxicity in cell culture. Given anti-biofilm effects are more relevant to combating P. acnes induced blemishes, this single bacteriophage was examined for its minimum biofilm eradication concentration (MBEC) of P. acnes biofilms. Initial tests showed a dose-dependent reduction in P. acnes biofilms that gradually reduced with repeated testing. This suggested a downside of this approach is that P. acnes could develop resistance. Additional species of P. acnes bacteriophage were produced, which restored the anti-biofilm activity and eliminated any sign of resistance. These findings confirm that P. acnes infections can be curtailed through application of a bacteriophage species uniquely targeted to the bacterium. From this, we conclude that further study is merited in utilizing bacteriophage as a bio-active component of a skin preparation to mitigate skin blemishes.

Figure 1. Overview of Propionibacterium acnes involved in the development of acne vulgaris.
A. Under normal, healthy conditions, the hair follicle is fine. B. Infection with P. acnes results in excess sebum production that results in distortion and inflammation of the pilosebaceous unit.


Figure 2. Overview of bacteriophage production process and clearance of P. acnes culture.
Schematic is shown that indicates the process by which bacteriophage specific to P. acnes will be cultivated, purified, and qualified. Graph of the absorbance at 600 nm of P. acnes cultures before and after incubation with P. acnes targeted bacteriophage. Absorbance drops more than half.

Figure 3. Bacteriophage in P. acnes culture.
A. Cooked meat medium (CMM) prior to inoculation with P. acnes bacteria against lined background to show translucency. B. P. acnes culture 48 h post-inoculation; note opacity against lined background. C. The P. acnes culture from B <24 h post-inoculation with bacteriophage specific for P. acnes; note return to translucency against the lined background. D. Side-by-side comparison of the initial CMM from A alongside the bacteriophage cleared P. acnes culture in C.

Figure 4. Propionibacterium acnes bacteriophage is not cytotoxic to skin cells.
Normal human keratinocytes (nHEK) were treated with multiple dilutions of two different P. acnes bacteriophage preparations and incubated over 72 hours. No cytotoxic effect was observed at all concentrations relative to untreated controls. *This was repeated for HaCaT and NHDF cell lines with the same outcome (data not shown)

Figure 5. Planktonic Assay.
P. acnes was grown to maximum turbidity in CMM from a colony isolate. The culture was applied at 96-well plate with 100 µL per well with control wells containing only CMM. The cultures were then mixed the indicated volumes of a single P. acnes phage prep and incubated at 37º C anaerobically for 48 hours. Abs. at 650 nm values shown.

Figure 6. Minimum Biofilm Eradication Concentration (MBEC) Assay.
Schematic of an MBEC assay system that tests the minimal amount of a bio-active material that can disrupt and eradicate a bacterial biofilm. Lids possessing pegs for insertion into 96-well plates are used to grow P. acnes biofilms, which are then subject to disruptive materials such as a bacteriophage.

Figure 7. MBEC Assay.
A. Blood agar plate with streaked culture of P. acnes exhibiting characteristic hemolytic pattern. Also, pegs from an MBEC plate from wells inoculated (a) or not (b) with P. acnes to confirm presence or absence of bacterial biofilms. B. Absorbance at 600 nm of residual bacteria shed from wells incubated with bacteriophage at indicated dilutions.
Figure 8. New P. acnes Bacteriophage Isolates.
Plaque assays showing results of environmental samples collected and evaluated from different locations for the presence of bacteriophage targeted to different strains of P. acnes. A. P. acnes phage isolated from Ljubljana, Slovenia and purified from 4 plaque picks to 7.73 x 10(7) PFU/mL. B. P. acnes phage isolated from Domzale, Slovenia and purified from 4 plaque picks to 3.33 x 10(8) PFU/mL.
CONCLUSIONS
• Bacteriophage targeted to P. acnes are easily produced and purified (Fig. 2); and very effectively destroy P. acnes indicated by conversion of cultures from turbidity to translucency (Fig. 3).
• The resulting preparations of P. acnes bacteriophage are non-cytotoxic (Fig. 4) and endotoxin-free (data not shown).
• Bacteriophage targeted to P. acnes can eliminate and disrupt both planktonic cells (Fig. 5) and biofilms (Fig. 6, 7).
• The development of resistance to a single P. acnes bacteriophage was surmounted via the introduction of additional P. acnes bacteriophage isolated from unique environmental samples.
REFERENCES
• M.J. Kim, D.H. Eun, S.M. Kim, J. Kim, and W.J. Lee. Efficacy of Bacteriophages in Propionibacterium acnes-induced Inflammation in Mice. (2019) Annals of Dermatology 31(1): 22-28.
• T. L. Brown, S. Petrovski, Z.A. Dyson, R. Seviour, and J. Tucci. The Formulation of Bacteriophage in a Semi-Solid Preparation for Control of Propionibacterium acnes Growth. (2016) PLoS One 11(3): 1-16.
• S. O’Flaherty, R.P. Ross, W. Meaney, G.F. Fitzgerald, M.F. Elbreki, and A. Coffey. Potential of the Polyvalent Anti-Staphylococcus Bacteriophage K for Control of Antibiotic-Resistant Staphylococci from Hospitals. (2005) Applied and Environmental Microbiology 71(4): 1836-1842.
Related Products


